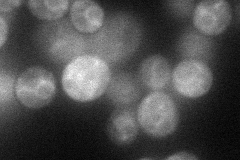
YGR212W
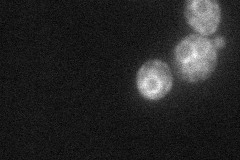
YGR212W
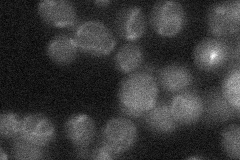
YGR212W

View description
N-acetyltransferase, confers resistance to the sphingolipid biosynthesis inhibitor myriocin (ISP-1) by converting it into N-acetyl-myriocin, co-operates with Ypk1p in mediating resistance to myriocin
Localization:
Intensity:
Fold change:
Significance:
-
C’ GFP library in SD

below threshold16.25 -
N' NOP1pr-GFP in SD
ER47.7696 -
N' TEF2pr-mCherry in SD
ER0 -
N' NATIVEpr-GFP in SD
below threshold21.5992 -
N' TEF2pr-VC and Cyto-VN in SD

#N/A0 -
C’ GFP library in SD+DTT

cytosol16.411No -
C’ GFP library in SD+H2O2

cytosol15.340.94No -
C’ GFP library in Starvation Media

cytosol13.240.81No -
C’ GFP library on the background of Pup2-DaMP

below threshold -
C’ GFP library on the background of CCT mutant

below threshold18.09961.1134No
